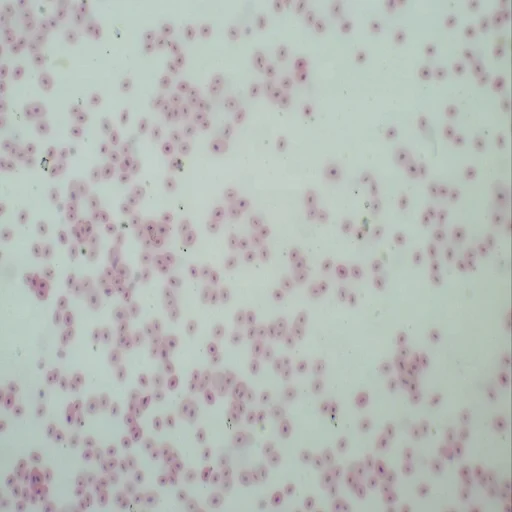
Microscope Slides - Zoology 100pcs Animal Prepared Slides High Quality Educational Supplies for Zoology

Microscope Slides Zoology 100pcs Animal Prepared Slides High Quality Educational Supplies for Zoology
- Category: Other Teaching Resources >>>
- Supplier: CENCE MEDIKAL VE TICARET LIMITED SIRKETI
Share on (62472458834):
Product Overview
Description
Zoology Prepared Microscope Slides
Ideal quality at affordable price.
Z1 Pig Adipose Cell w.m.
Z2 Mouse Cuboidal Epithelium sec.
Z3 Dog Colurmar Epithelium sec.
Z4 Dog Cohuunar Ciliated
Z5 Paramecium-Conjugation w.m.
Z6 Paramecium-Fission w.m.
Z7 Hydra I.s.
Z8 Hydra Plain and Budding w.m.
Z9 Planaria c.s.
Z10 Blood Fluke-Eggs w.m.
Z11 Taenia Pisiformis w.m.
Z12 Ascaris c.s.
Z13 Mosquito-Female w.m.
Z14 Mole Cricket Leg w.m.
Z15 Mantis Leg w.m.
Z16 Dog Tongue I.s.
Z17 Dog Stomach Cardiac Region sec
Z18 Dog Stomach Pyloric Region sec
Z19 Pig Liver sec
Z20 Rabbit Venae Cavac c.s.
Z21 Mouse Kidney sec.
Z22 Dog Urinary Bladder sec.
Z23 Human Skin-Hair-Follice sec.
Z24 Rabbit Ganglia sec.
Z25 Dog Olfactory Membrane sec.
Z26 Mouse Ovary sec.
Z27 Frog Spermatozoa s.m.
Z28 Bulgarious s.m.
Z29 Striated Muscle c.s.
Z30 Planaria w.m.
Z31 Dense Connective Tissue sec.
Z32 Loose Connective Tissue sec.
Z33 Aspergillus w.m.
Z34 Lung-Injected (Rabbit) sec.
Z35 Kidney-Injected (Rabbit) sec.
Z36 Ant w.m.
Z37 Mosquito-Male w.m.
Z38 Mosquito-Eggs w.m.
Z39 Drosophila-Female w.m.
Z40 Drosophila-Male w.m.
Z41 Drosophila-Larva w.m.
Z42 Drosophila-Chrysalis w.m.
Z43 Frog-Vnsegmented egg sec.
Z44 Frog-Holoblastic Cleavage sec.
Z45 Frog-Cleavage sec.
Z46 Frog-Blastule sec.
Z47 Feather w.m.
Z48 Fibre w.m.
Z49 House Fly Leg w.m.
Z50 House Fly Wing w.m.
Z51 Butterfly Leg w.m.
Z52 Ascarid Egg w.m.
Z53 Frog-Early Gastrula sec.
Z54 Frog-Gastrula sec.
Z55 Ant w.m.
Z56 Silkworm Moth Antennae w.m.
Z57 Peach worm w.m.
Z58 Butterfly Antennae w.m.
Z59 Cotton Worm w.m.
Z60 Shrimp-Egg w.m.
Z61 Letter "E" w.m.
Z62 Root Bacteria c.s.
Z63 Typical Animal Cell
Z64 Ciliated Epithelium sec.
Z65 Human Cell Mucus Membrane s.m.
Z66 Frog Epidermic Cell sec.
Z67 Dog squamous Epitheblium w.m.
Z68 Paramecium w.m.
Z69 Hydra c.s.
Z70 Earthworm c.s.
Z71 Daphina w.m.
Z72 Mosquito Larva w.m.
Z73 Mosquito Mouth Parts w.m.
Z74 Honeybee Mouth parts w.m.
Z75 Housefly Mouth Parts w.m.
Z76 Honeybee Worker Leg-Composite w.m.
Z77 Mosquito Wings w.m.
Z78 Butterfly Wings Ocales w.m.
Z79 Dragonfly Wings w.m.
Z80 Honeybee Wings w.m.
Z81 Housefly Compound Eye w.m.
Z82 Honeybee Compound Eye w.m.
Z83 Dragonfly Compound Eye w.m.
Z84 Dog Esophagus c.s.
Z85 Dog Small Intestine sec.
Z86 Dog Stomach sec.
Z87 Dog Duodenum c.s.
Z88 Dog Jejunum c.s.
Z89 Dog Ileum c.s.
Z90 Dog Rectum c.s.
Z91 Dog Spleen sec.
Z92 Dog Pancreas sec.
Z93 Pig Gall Bladder sec.
Z94 Rabbit Artery abd Vein c.s.
Z95 Rabbit Arteriole c.s.
Z96 Human Blood s.m.
Z97 Frog Blood s.m.
Z98 Fish Blood s.m.
Z99 Rabbit Lymph Node sec.
Z100 Dog Trachea c.s.
The plastic box packed in carton with foam.
We Recommend
New Arrivals
New products from manufacturers at wholesale prices